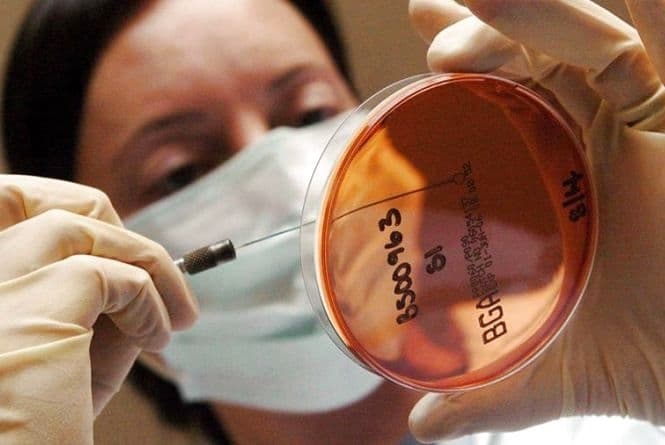
Чому на Львівщині стався спалах сальмонельозу

Новини з тегом #отруєння
У Львові ще двоє госпіталізованих після їжі в шкільній їдальні. Один - через контакт із хворим
У Львові ще двоє госпіталізованих після їжі в шкільній їдальні. Один - через контакт із хворим
12 листопада 2025, 13:58
CityLifeУ Львові зросла кількість учнів, які потрапили до лікарні після харчування у шкільній їдальні
У Львові зросла кількість учнів, які потрапили до лікарні після харчування у шкільній їдальні
11 листопада 2025, 14:11
CityLifeУ Львові госпіталізували 14 учнів з кишковою інфекцією після харчування в їдальні
У Львові госпіталізували 14 учнів з кишковою інфекцією після харчування в їдальні
10 листопада 2025, 13:50
CityLifeЗросла кількість госпіталізованих дітей через отруєння в готелі в Славському
Зросла кількість госпіталізованих дітей через отруєння в готелі в Славському
19 серпня 2025, 10:11
CityLifeТретій випадок за місяць. У готелі на Львівщині масово отруїлися діти
Третій випадок за місяць. У готелі на Львівщині масово отруїлися діти
18 серпня 2025, 09:24
CityLifeПісля масового отруєння у Львові ресторан «Китайський привіт» оштрафували
Після масового отруєння у Львові ресторан «Китайський привіт» оштрафували
12 серпня 2025, 12:53
CityLifeНоровірус у воді з кулера. Що відомо про масове отруєння у таборі на Львівщині
Норовірус у воді з кулера. Що відомо про масове отруєння у таборі на Львівщині
11 серпня 2025, 10:55
CityLifeМасове отруєння у таборі в Славську. У лікарні розповіли про стан дітей
Масове отруєння у таборі в Славську. У лікарні розповіли про стан дітей
05 серпня 2025, 15:20
CityLifeЗа чотири місяці 64 людини отруїлись чадним газом у Львові
За чотири місяці 64 людини отруїлись чадним газом у Львові
28 квітня 2025, 10:53
CityLife12-річна дівчинка отруїлася чадним газом у Львові
12-річна дівчинка отруїлася чадним газом у Львові
23 квітня 2025, 10:03
CityLifeДвоє дітей у Львові та області отруїлись чадним газом
Двоє дітей у Львові та області отруїлись чадним газом
19 квітня 2025, 12:01
CityLifeБіля Львова сім'я отруїлася чадним газом. Одна людина загинула
Біля Львова сім'я отруїлася чадним газом. Одна людина загинула
05 квітня 2025, 12:15
CityLifeУ Львові 44 людини отруїлись чадним газом від початку року
У Львові 44 людини отруїлись чадним газом від початку року
31 березня 2025, 18:45
CityLifeУ квартирі на Сихові троє людей отруїлись чадним газом, серед них дитина
У квартирі на Сихові троє людей отруїлись чадним газом, серед них дитина
28 березня 2025, 10:28
CityLifeЧерез отруєння чадним газом у Львові та області госпіталізували 5 дітей
Через отруєння чадним газом у Львові та області госпіталізували 5 дітей
23 березня 2025, 12:47
CityLifeЧетверо людей отруїлися чадним газом у Львові, в тому числі 3-річна дитина
Четверо людей отруїлися чадним газом у Львові, в тому числі 3-річна дитина
19 квітня 2024, 10:24
CityLifeВ Києві діти отруїлись шоколадом з канабісом і псилоцибіном
В Києві діти отруїлись шоколадом з канабісом і псилоцибіном
05 квітня 2024, 17:24
Двоє людей загинули від отруєння чадним газом
Двоє людей загинули від отруєння чадним газом
19 грудня 2023, 11:33
CityLifeУ Львові сім'я з дітьми отруїлась чадним газом
У Львові сім'я з дітьми отруїлась чадним газом
28 листопада 2023, 11:23
ОсвітаНа Львівщині внаслідок отруєння чадним газом загинуло 5 людей. Як вберегтись
На Львівщині внаслідок отруєння чадним газом загинуло 5 людей. Як вберегтись
08 жовтня 2023, 09:41
CityLifeПіцерія в автостанції на Подолі в Києві перепросила у десяти відвідувачів, які отруїлись в закладі
Піцерія в автостанції на Подолі в Києві перепросила у десяти відвідувачів, які отруїлись в закладі
21 липня 2023, 11:50
У Києві зафіксували спалах гострої кишкової інфекції
У Києві зафіксували спалах гострої кишкової інфекції
18 липня 2023, 18:35
Дев'ятеро мешканців Львівщини отруїлися в Яремчі
Дев'ятеро мешканців Львівщини отруїлися в Яремчі
06 липня 2023, 22:55
CityLifeНа Львівщині з відпочинкового комплексу госпіталізували дітей з отруєнням
На Львівщині з відпочинкового комплексу госпіталізували дітей з отруєнням
07 квітня 2023, 13:13
ОсвітаКількість хворих у модульному містечку на Сихові знову зросла
Кількість хворих у модульному містечку на Сихові знову зросла
06 березня 2023, 19:10
CityLifeОтруєння в кафе «Альпака» в Києві: заклад відреагував на інцидент
Отруєння в кафе «Альпака» в Києві: заклад відреагував на інцидент
16 лютого 2023, 18:31
У Києві отруїлися у закладі харчування: п'ятеро осіб перебувають у лікарні із сальмонельозом
У Києві отруїлися у закладі харчування: п'ятеро осіб перебувають у лікарні із сальмонельозом
15 лютого 2023, 23:41
Отруєння яйцями: у кафе Honey розказали про результати дослідження
Отруєння яйцями: у кафе Honey розказали про результати дослідження
07 лютого 2023, 09:32
Двоє сестер з Київщини померли від отруєння грибами
Двоє сестер з Київщини померли від отруєння грибами
01 вересня 2022, 16:07
На Львівщині через масове отруєння до лікарні потрапило семеро переселенців
На Львівщині через масове отруєння до лікарні потрапило семеро переселенців
30 серпня 2022, 14:17
CityLifeУ Львові назвали причину масового отруєння у ресторанах «Томатіна»
У Львові назвали причину масового отруєння у ресторанах «Томатіна»
27 липня 2022, 11:15
CityLifeУ частини потерпілих від отруєння в закладах «Tomatina» у Львові виявили сальмонелу
У частини потерпілих від отруєння в закладах «Tomatina» у Львові виявили сальмонелу
14 липня 2022, 11:09
CityLifeМедики розповіли про стан госпіталізованих унаслідок отруєння в львівській мережі ресторанів
Медики розповіли про стан госпіталізованих унаслідок отруєння в львівській мережі ресторанів
11 липня 2022, 13:02
CityLifeКількість постраждалих від отруєння у львівській мережі ресторанів зросла до 29
Кількість постраждалих від отруєння у львівській мережі ресторанів зросла до 29
11 липня 2022, 10:12
CityLifeНа Львівщині – два нових випадки ботулізму. Як запобігти хворобі
На Львівщині – два нових випадки ботулізму. Як запобігти хворобі
07 липня 2022, 08:05
CityLifeУ дитсадку на Львівщині отруїлося четверо дітей
У дитсадку на Львівщині отруїлося четверо дітей
16 лютого 2022, 16:06
CityLifeУ центрі Львова чадним газом отруїлися двоє людей. Як не допустити трагедії
У центрі Львова чадним газом отруїлися двоє людей. Як не допустити трагедії
16 січня 2022, 09:35
CityLifeЧетверо дітей із притулку отруїлися в ресторані біля Львова
Четверо дітей із притулку отруїлися в ресторані біля Львова
21 грудня 2021, 09:55
CityLifeНа Львівщині у спорткомплексі масово отруїлися діти
На Львівщині у спорткомплексі масово отруїлися діти
18 серпня 2021, 09:10
CityLifeЧому на Львівщині стався спалах сальмонельозу
Чому на Львівщині стався спалах сальмонельозу
14 липня 2021, 18:00
ОсвітаКількість людей, які отруїлися в ресторані на Львівщині, зросла до 17. Оновлено
Кількість людей, які отруїлися в ресторані на Львівщині, зросла до 17. Оновлено
07 липня 2021, 13:09
CityLifeНебезпека навколо нас. Як захистити дітей від кишкових інфекцій
Небезпека навколо нас. Як захистити дітей від кишкових інфекцій
07 червня 2021, 21:00
ОсвітаУ Львові в дитсадку виявили спалах кишкової інфекції
У Львові в дитсадку виявили спалах кишкової інфекції
06 березня 2021, 10:00
CityLifeСім кіл пекла. Мама дівчинки, яка отруїлася соком, досі не може добитися справедливості
Сім кіл пекла. Мама дівчинки, яка отруїлася соком, досі не може добитися справедливості
12 лютого 2021, 14:02
CityLifeПоліція відкрила кримінальне провадження через ситуацію у дитсадку біля Львова
Поліція відкрила кримінальне провадження через ситуацію у дитсадку біля Львова
08 лютого 2021, 17:36
ОсвітаНа Львівщині дитина отруїлася соком з пліснявою
На Львівщині дитина отруїлася соком з пліснявою
06 лютого 2021, 14:15
CityLifeУ Львові чадним газом отруїлася 15-річна дівчина
У Львові чадним газом отруїлася 15-річна дівчина
13 грудня 2020, 11:57
CityLifeНа Львівщині змія вкусила за ногу 8-річного хлопчика
На Львівщині змія вкусила за ногу 8-річного хлопчика
30 серпня 2020, 13:14
CityLifeНа Львівщині у лікарню з отруєнням потрапили працівники одного з підприємств
На Львівщині у лікарню з отруєнням потрапили працівники одного з підприємств
18 лютого 2020, 15:52
Освіта15 туристів, які отруїлись у Славському на Львівщині, виписались із лікарні
15 туристів, які отруїлись у Славському на Львівщині, виписались із лікарні
13 лютого 2020, 10:40
ОсвітаКонтент
Рубрики
Розроблено:
Levprograming
За умови повного або часткового використання iнформацiї гіперпосилання на tvoemisto.tv є обов'язковим. Відповідальність за достовірність фактів, цитат, власних імен та інших відомостей несуть автори публікацій, а рекламної інформації — рекламодавці. Думка редакцiї може не збiгатися з думкою авторiв.
© 2026 "Твоє місто"